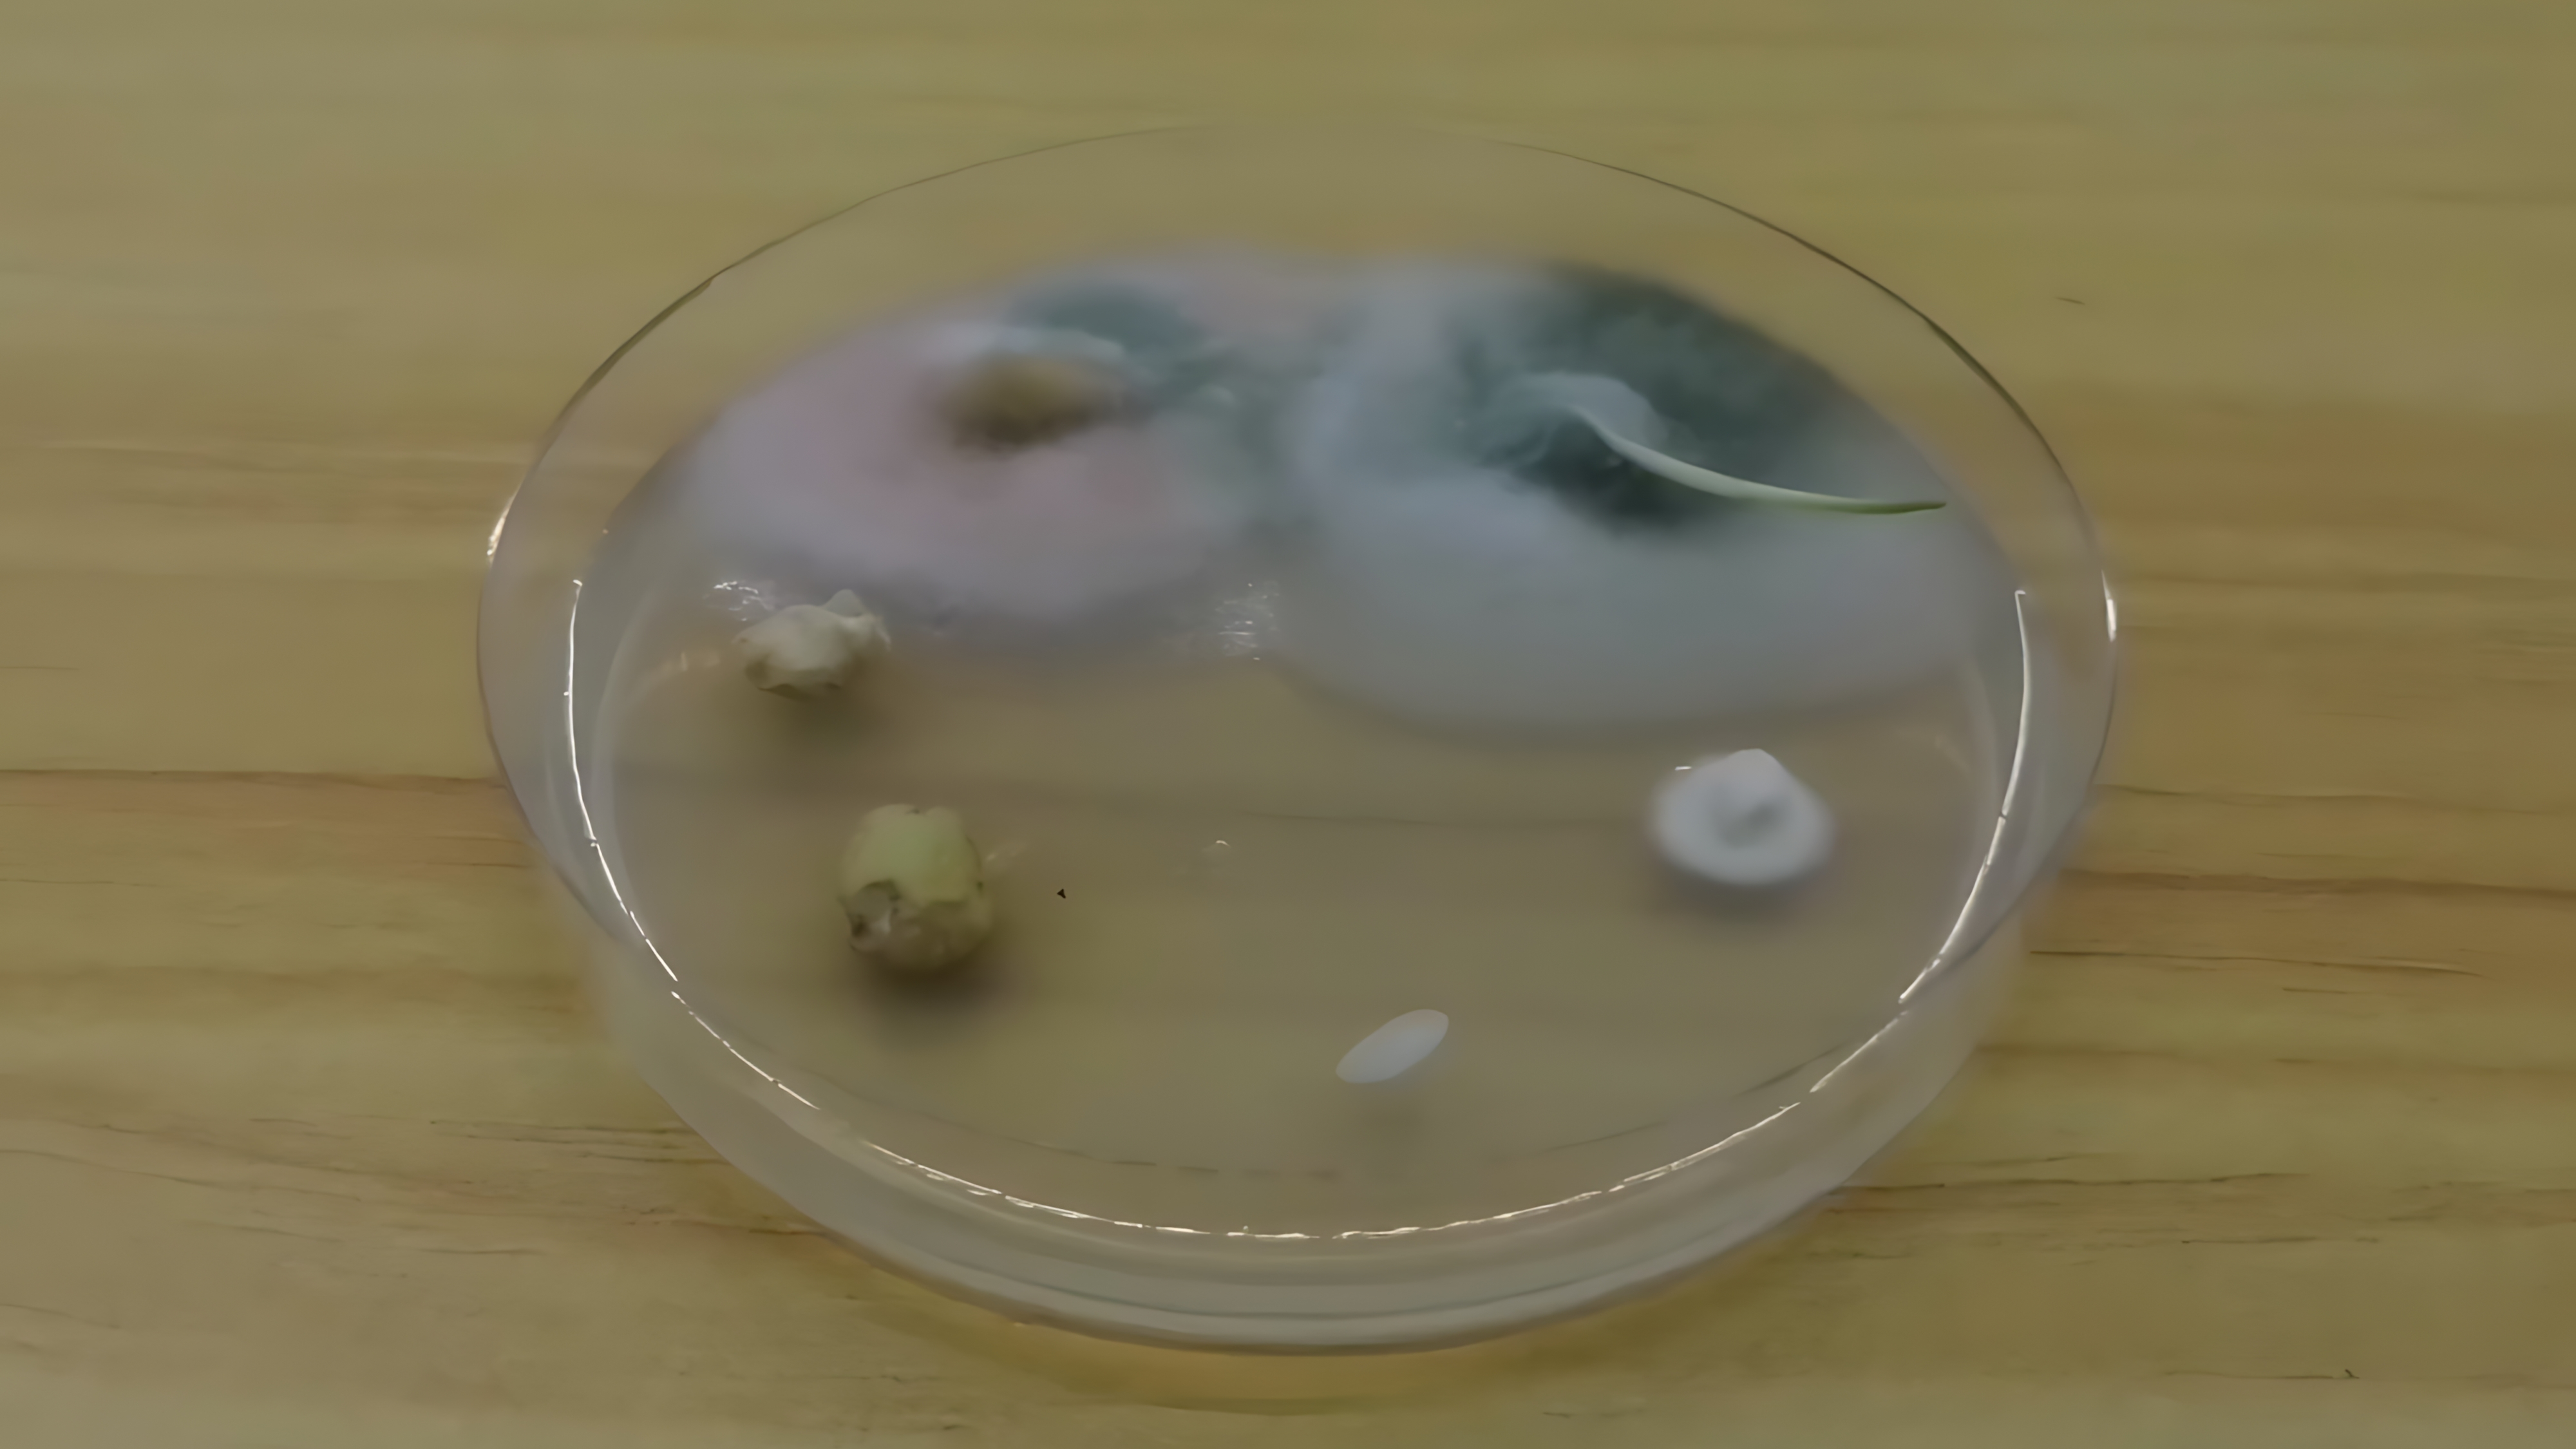

Триходерма своими руками? Да. Делаем годовой запас мощного биофунгицида из пачки перловки
Каждый, кто всерьез занимается огородом, знает главных врагов урожая в лицо: фитофтора, фузариоз, всевозможные корневые гнили… Бороться с ними можно дорогой «химией», а можно — с помощью мощного биологического союзника, гриба Триходерма. Готовые препараты в магазинах стоят недешево, а их концентрация часто оставляет желать лучшего. Но что, если я скажу вам, что можно самостоятельно вырастить литры этого биофунгицида с высокой активностью, потратив на это дело совсем немного денег?
В этом материале поделюсь своим методом наращивания чистой культуры триходермы на обычной перловке. Это просто, доступно и очень эффективно.

Что нам понадобится? (Арсенал био-лаборатории)
Никакого сложного оборудования не потребуется. Для нашей домашней био-лаборатории понадобится самая обычная и дешевая перловка — она станет идеальной питательной средой. Для замачивания подойдут простые пищевые ведра или кастрюли, а для стерилизации — термостойкие рукава или пакеты для запекания. Самое главное правильно выбрать материал для размножения. Нужен не порошок из магазина, а именно чистая культура триходермы, выращенная на агаре в чашке Петри. Завершает наш арсенал набор простых инструментов: кухонные весы, ложка, пинцет, нож и газовая горелка для стерилизации.
Подготовка и стерилизация — самый важный этап
Фундамент всего процесса. Наша цель — не сварить кашу, а стерилизовать зерно, убив на нем все конкурирующие грибки и бактерии, чтобы наша триходерма росла в чистой среде.
- Промывка. Перловка из магазина довольно грязная. Тщательно промываем ее в ведрах 3-4 раза, пока вода не станет относительно прозрачной.
- Замачивание. Заливаем промытую крупу чистой водой и оставляем на 12 часов для набухания.
- Слив и финальная промывка. Спустя 12 часов крупа разбухнет. Сливаем воду и еще раз промываем перловку.
- Расфасовка. Раскладываем влажную крупу по пакетам для запекания. Из опыта, оптимальный вес — около 700-800 грамм на один пакет.
- Стерилизация. Помещаем пакеты в холодную духовку. Пакеты не завязываем, а просто подворачиваем край, чтобы пар мог выходить. Выставляем температуру 190-200°C и таймер на 1.5 часа. После окончания прогрева духовку не открываем! Оставляем пакеты остывать прямо в ней, медленно, в течение нескольких часов. Такой эффект «русской печи» обеспечивает дополнительную пастеризацию.

Почему нельзя просто сварить кашу? Наглядный эксперимент
Многие спрашивают: зачем такие сложности? Почему не сварить перловку или не залить кипятком? Ответ прост: на поверхности любого зерна живут споры других грибов, и простая варка их не убьет.
Чтобы доказать это, я провел эксперимент. В стерильную чашку Петри с питательной средой я положил несколько зерен перловки, риса и гороха прямо из пакета, без всякой обработки.
Через несколько дней зерна покрылись колониями плесени. Характерный розовый налет на левом зерне перловки — это гриб Fusarium, один из самых опасных патогенов, вызывающий корневые гнили. Если вы просто сварите кашу, вы не убьете его споры, а наоборот, создадите для них идеальную питательную среду. Вместо полезной триходермы вы рискуете разнести по своему огороду биологическое оружие. Именно поэтому тщательная стерилизация в духовке — самый надежный и доступный в домашних условиях путь.
Заселение (инокуляция) и DIY-фильтр
Это самый ответственный момент, требующий максимальной чистоты. Работаем в перчатках, все инструменты и поверхности обрабатываем спиртом. Когда остывший после стерилизации пакет с перловкой готов, стерильным пинцетом (прокаленным над огнем горелки) берем небольшой кусочек агара с мицелием и бросаем его внутрь пакета.
Теперь нужно обеспечить грибу доступ к воздуху, но защитить от заражения. Для этого я делаю гениальный в своей простоте DIY-фильтр. Беру обычную картонную втулку от туалетной бумаги, вставляю ее в собранную горловину пакета, накрываю сверху чистой бумажной салфеткой и плотно фиксирую все это резинкой. Такой самодельный фильтр отлично пропускает воздух, но задерживает споры плесени и бактерии.

Инкубация, рост и хранение
Теперь остается только ждать. Убираем пакеты в темное теплое место, и уже через два-три дня зерно начнет покрываться нежным белым пушком — это мицелий триходермы. На этом этапе очень важно аккуратно, прямо через пакет, перетряхнуть и размять содержимое, чтобы равномерно распределить грибницу по всему объему. Этот простой прием в разы ускорит колонизацию. Спустя еще несколько дней, примерно через неделю после заселения, весь субстрат покроется плотным белым мицелием, а затем начнет зеленеть. Насыщенный зеленый цвет — это сигнал, что триходерма начала спороносить, и у вас в руках готовый, высокоактивный препарат.

Готовый продукт нужно пересыпать из полиэтиленовых пакетов в бумажные крафт-пакеты, чтобы зерно могло «дышать» и подсыхать. В таком виде, в сухом и прохладном месте, препарат сохраняет свою активность несколько месяцев.
Как это использовать?
Способов применения множество. Самый простой — приготовить маточный раствор. Берем горсть (50-100 г) готового зерна на 10 литров воды, настаиваем пару часов, периодически перемешивая, процеживаем и используем для полива растений под корень или опрыскивания по листу. Также можно вносить по несколько зерен непосредственно в лунку при посадке рассады.
На этом все. Удачи в ваших агрономических экспериментах.
Источник: камера смартфона











4 комментария
Добавить комментарий
Кусочек агара с мицелием у каждого огородника конечно в загашнике всегда имеется.
Вот и тут у вас так — самый ключевой факт просто обойден стороной — где взять «стартовую» культуру-то высокого (лабораторного?) качества?
Меня это волнует, так как третий год подряд теряем минимум четверть урожая помидор из-за фитофторы (с другой стороны, эффективность по фитофторе у триходермы всё равно сомнительная, судя по статьям которые я нашёл, фитофтора, сволочь такая, не грибок же).
Добавить комментарий